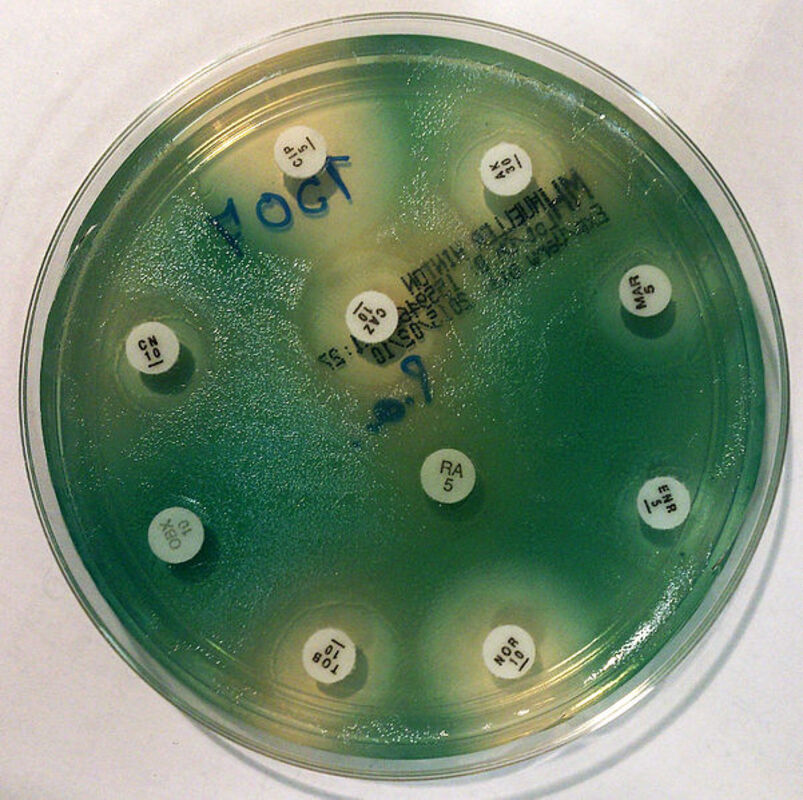
Pseudomonas aeruginosa гораздо быстрее, чем обычно, развивает резистентность к распространенному антибиотику "последнего выбора"

Исследование, опубликованное 7 июня в журнале Cell Reports, показывает, как популяции Pseudomonas aeruginosa реагируют на воздействие колистином, антибиотиком "последнего выбора" для пациентов, у которых развились инфекции с множественной лекарственной резистентностью.
Соавтор работы профессор Крейг Маклин, с факультета биологии Оксфордского университета, сообщил: "Наша работа показала, что ген, участвующий в резистентности к колистину, мутирует с невероятно высокой скоростью, что позволяет бактериям быстро развивать резистентность к антибиотикам. Наше исследование предполагает, что в данном конкретном случае селективное давление, вызванное связью этого гена с иммунной системой, могло привести к эволюции сверхбыстрой скорости мутаций, что приводит к развитию резистентности бактерий к антибиотикам".
Авторы изучили реакцию ≈1000 популяций штамма P. aeruginosa с множественной лекарственной резистентностью на высокую дозу колистина. Подсчитав бактерии и секвенировав их геномы, исследователи смогли оценить, как быстро у разных популяций развилась резистентность к антибиотику и какая генетическая мутация вызвала резистентность.
Результаты показали, что воздействие колистина вызвало быструю гибель клеток, но некоторые популяции в конечном итоге восстановились за счет роста субпопуляций гетерорезистентных клеток. Гетерорезистентность нестабильна, и резистентность быстро пропадала при культивировании в среде без колистина. Авторы показали, что эволюция гетерорезистентности была в основном обусловлена отбором на гетерорезистентность в двух горячих точках в регуляторной системе PmrAB. Локализованная гипермутация pmrB создавала резистентность к колистину с частотой мутаций в 103–104 раза выше фоновой (≈2 × 10-5 на одно деление клетки). PmrAB обеспечивал резистентность к антимикробным пептидам, участвующим в иммунитете хозяина, что позволяет предположить, что этот патоген мог эволюционировать с высокой мутабельностью pmrB в качестве адаптации к иммунитету хозяина.
Хотя бактерии развивали резистентность к колистину гораздо быстрее, чем ожидалось, исследование выявило и положительный результат. Когда антибиотик был отменен, популяции патогенов быстро утратили резистентность вследствие высокой скорости мутаций. Авторы планируют расширить свое исследование и выяснить, какие другие свойства Pseudomonas могут быть вовлечены в создание такого высокого уровня резистентности к противомикробным препаратам.